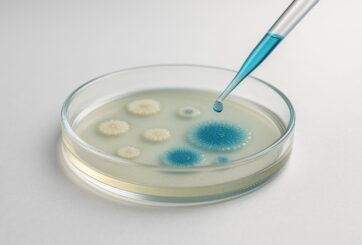
AI Generated Image

In the immune system’s fight against cancer and infections, the T cells often lose their power. The team of Würzburg immunologist Martin Vaeth has found a possible explanation for this phenomenon. In the immune system, chronic infections and the defence against tumors often lead to the phenomenon of T cell exhaustion: In this process, the T lymphocytes gradually lose their function, which impairs their responses against cancer and infections. The molecular mechanisms that control this loss of function have not…

On Nov. 1, NASA’s Lucy spacecraft flew by not just its first asteroid, but its first two. The first images returned by Lucy reveal that the small main belt asteroid Dinkinesh is actually a binary pair. “Dinkinesh really did live up to its name; this is marvelous,” said Hal Levison, referring to the meaning of Dinkinesh in the Amharic language, “marvelous.” Levison is principal investigator for Lucy from the Boulder, Colorado, branch of the San-Antonio-based Southwest Research Institute. “When Lucy was originally…

A broken bone failing to heal represents an enormous burden for patients. Fraunhofer researchers have worked alongside partners to develop a composite material to be used in the treatment of such non-union cases. The resulting implant is designed to significantly improve treatment success rates and speed up the healing process. The material is made up of a combination of a biodegradable polymer and bioactive glass and can serve as a main and supporting structure. Its aim is to inhibit the…

International team of researchers reveals for the first time a mechanism to explain pronounced climate variability during the last ice age. Although humankind is responsible for the current global climate warming, our planet has constantly been undergoing natural climate fluctuations throughout the past. Possible forcing mechanisms for this variability would have been changes in the brightness of the sun or explosive volcanic eruptions, but also interactions within the atmosphere/ocean/sea-ice system. Experts refer here to external and internal factors influencing the…

The U.S. Naval Research Laboratory’s Melanized Microbes for Multiple Uses in Space Project, or MELSP, will use the International Space Station (ISS) to search for production of melanin variants and other useful biomaterials that can have applications both on Earth and in space. The mission is scheduled to launch in early November 2023. Melanin is described as a group of biopolymers responsible for various biological functions, including pigmentation of skin, hair, and iris of the eyes, which helps protect body…

Honored with Georg Waeber Innovation Award 2023. A team from Rigaku SE and Fraunhofer IISB has established a new semiconductor material characterization method. They succeeded in developing an industry-ready X-ray topography system and in employing defect detection and quantification algorithms, achieving a unique material characterization method for silicon carbide (SiC) wafers. SiC is an excellent semiconductor for application areas like electric mobility, energy supply, industrial infrastructure up to sensors and quantum technologies. Now, Dr. Kranert and Dr. Reimann from Fraunhofer…

What potential do 6G and AI unfold? We are already experiencing the shortage of physicians and its consequences for patient care. Can mobile surgical robots provide a solution? Combining approaches from robotics with AI methods using the future mobile communications standard 6G, researchers at RPTU and the German Research Center for Artificial Intelligence (DFKI) are investigating this question. Their objective: An analysis that shows potentials of remote-controlled robotics for surgical operations and defines requirements for AI and communication networks. The…

Researchers demonstrate solution for long-term challenge. In a paper published recently in Advanced Science, researchers from the Paul Drude Institute in Berlin, Germany, and the Xiamen University, Xiamen, China, demonstrated that ferrimagnetic NiCo2O4 (NCO) constitutes a solution for the long-term challenge of finding materials with a robust out-of-plane magnetization. Furthermore, it is shown that the electrical and magnetic characteristics of NCO can be tailored in wide ranges. The research team also resolved the origin of an unusual fundamental magnetotransport phenomenon….
Smartbax nominated for Falling Walls award. It all began with basic research: While conducting laboratory experiments, a team at the Technical University of Munich (TUM) came across an active agent against multidrug-resistant bacteria with a fundamental difference to antibiotics developed to date. The researchers have since established a start-up to develop a new drug based on this agent. The entrepreneurs have now been nominated for Science Breakthrough of the Year in the Science Start-Up category at the international Falling Walls…

New insights through expression of foreign proteins. A German-French research team led by Bayreuth microbiologist Dirk Schüler presents ground-breaking new findings on the functionality of proteins in magnetic bacteria in the journal “mBio”. The research is based on previous results published recently in the same journal. In this study, the Bayreuth scientists used bacteria of the species Magnetospirillum gryphiswaldense to decipher the function of genes that are presumably involved in the biosynthesis of magnetosomes in other magnetic bacteria that are…

Researchers at Johannes Gutenberg University Mainz are investigating the jet stream to assess how its decadal variations could affect the occurrence of weather extremes in Europe. Heavy precipitation, wind storms, heat waves – when severe weather events such as these occur they are frequently attributed to a wavy jet stream. The jet stream is a powerful air current in the upper troposphere that balances the pressure gradient and Coriolis forces. It is still uncertain whether the jet stream is really…

Molybdenum disulphide (MoS₂) is a highly versatile material that can function, for example, as a gas sensor or as a photocatalyst in green hydrogen production. Although the understanding of a material usually starts from investigating its bulk crystalline form, for MoS₂ much more studies have been devoted to mono and few layer nanosheets. The few studies conducted thus far show diverse and irreproducible results for the electronic properties of cleaved bulk MoS₂ surfaces, highlighting the need for a more systematic…

The open-source platform “Open Twins” simulates environments and enables the analysis of the behavior of real-world assets based on virtual replicas. The next-gen “digital twins” are created at the University of Malaga. Three engineers from the research group “ERTIS” have developed an open-source platform, more accessible and versatile, that enables the design of these technological tools that simulate real environments based on virtual replicas. We refer to ‘Open Twins’, the first open-source integrated ecosystem of “digital twins”, which is able…

Finding the best material to make solar cells is a colossal task, but a research team at Osaka University has been using robotic systems and AI to make the search faster and more efficient. Solar energy is one of the most promising ways to power the world of the future. However, creating more efficient solar cells requires finding new and better materials. Now, in a study recently published in JACS Au, researchers at Osaka University have unveiled a solution: a…

In a new study, a group of researchers, led by Dr. Joshua Goldberg from the Hebrew University, describe a new kind of neurochemical wave in the brain. Their research, published in Nature Communications, unveils the existence of traveling waves of the neurochemical acetylcholine in the striatum, a region of the brain responsible for motivating actions and habitual behaviors. The motivation to execute an action is widely thought to depend on the release of the another neurochemical, dopamine, in the striatum….

… could help reduce costs. Researchers have developed a new method for 3D printing metal that could help reduce costs and make more efficient use of resources. The method, developed by a research team led by the University of Cambridge, allows structural modifications to be ‘programmed’ into metal alloys during 3D printing, fine-tuning their properties without the ‘heating and beating’ process that’s been in use for thousands of years. The new 3D printing method combines the best qualities of both…